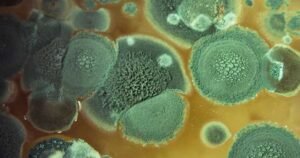

അതീവ അപകടം നിറഞ്ഞ രോഗാണുക്കളെ യുഎസിലേക്ക് കടത്തിയ രണ്ട് പേർ പിടിയിൽ. യുൻക്വിങ് ജിയാൻ (33), സുഹൃത്തായ സുൻയോങ് ലിയു (34) എന്നിവർക്ക് എതിരയാണ് കേസ്. ഇവർ ചൈനീസ് പൗരന്മാരാണ്. ‘ഫ്യൂസേറിയം ഗ്രാമിനീറം’ എന്ന ഫംഗസ് യുഎസിലേക്ക് കടത്തിയെന്ന പരാതിയെ തുടർന്നാണ് എഫ്ബിഐ ഇരുവരെയും അറസ്റ്റ് ചെയ്തത്. ഗോതമ്പ്, ബാർളി, ചോളം, അരി എന്നിവയെ ബാധിക്കുന്ന ‘ഹെഡ് ബ്ലൈറ്റ്’ എന്ന ഫംഗസ് ഉണ്ടാക്കുന്ന രോഗാണു കോടിക്കണക്കിന് ഡോളറിന്റെ സാമ്പത്തിക നഷ്ടത്തിന് കാരണമാകുമെന്നും റിപ്പോർട്ടിൽ പറയുന്നുണ്ട്. ഗൂഢാലോചന, തെറ്റായ … Continue reading അപകടകാരികളായ രോഗാണുക്കളെ യുഎസിലേക്ക് കടത്തി; യുവാവും യുവതിയും അറസ്റ്റിൽ; പടർന്നുപിടിച്ചാൽ പ്രതിവിധികളില്ല..!